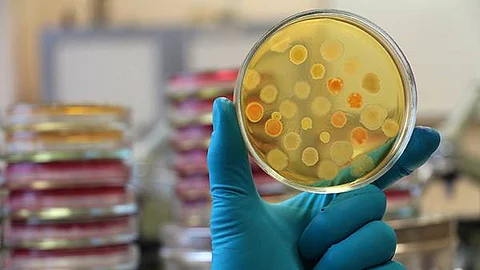
കൊവിഡ് ഒരു മനുഷ്യനിർമ്മിത വൈറസ് ആണോ?

കൊവിഡ് ഒരു മനുഷ്യനിർമ്മിത വൈറസ് ആണോ?
2018-ലെ വൈദ്യശാസ്ത്രത്തിനുള്ള നോബൽ സമ്മാന ജേതാവായ പ്രൊഫസർ ടോസുകോ ഹോൺജോ എന്ന ജാപ്പാനീസ് ശാസ്ത്രജ്ഞൻ ഇങ്ങനെ പറഞ്ഞതായാണ് ഇപ്പോൾ ധാരാളമായി പ്രചരിക്കുന്ന വാർത്തകൾ. അദ്ദേഹത്തിൻ്റെ പേരിലുള്ള ട്വീറ്റ് വഴി വന്ന ആ സന്ദേശത്തിൻ്റെ ഏകദേശ സംഗ്രഹം ഇങ്ങനാണ്,
'ഇതൊരു മനുഷ്യനിർമ്മിത വൈറസ് ആണ്. അതുകൊണ്ടാണ് അത് പല കാലാവസ്ഥകളുള്ള പല രാജ്യങ്ങളിലും ഇത്രയും മരണ കാരണമാകുന്നത്. വുഹാനിലെ ലാബിൽ ഞാൻ 4 വർഷം ജോലി ചെയ്തതാണ്. അവിടെ പലരുമായും ഇപ്പോഴും ബന്ധമുള്ളതാണ്. പക്ഷേ ഇപ്പോൾ അവരാരും വിളിച്ചിട്ട് ഫോൺ എടുക്കുന്നില്ല. അവരുടെ ഫോൺ എല്ലാം നിലച്ചു പോയിരിക്കുന്നു. അതിനർത്ഥം അവരെല്ലാം രോഗം വന്ന് മരിച്ചു പോയി എന്നാണ്.'
ഈ സന്ദേശം പ്രചരിപ്പിക്കുന്നത് നല്ല വിദ്യാഭ്യാസമുള്ളവരും അധ്യാപകരും രാഷ്ട്രീയക്കാരും ഒക്കെ തന്നെയാണ്. നോബൽ സമ്മാന ജേതാവ് പറഞ്ഞതുകൊണ്ട് തന്നെ അവർക്കാർക്കും സംശയം ഒട്ടുമില്ല. എന്താണ് അതിൻ്റെ സത്യാവസ്ഥ എന്നറിയാൻ ആർക്കാണിവിടെ താൽപ്പര്യം? ഇത്തിരി ഉപ്പും മുളകുമുള്ള വാർത്തയാണെങ്കിൽ അതെത്രയും വേഗം ഷെയർ ചെയ്തില്ലേൽ വല്ലാത്തൊരേനക്കേടാ..
എന്താണിതിൻ്റെ യാഥാർത്ഥ്യം?
1.ആ സന്ദേശം വന്ന ട്വിറ്റർ ഹാൻഡിൽ വെരിഫൈഡ് അല്ല. അത് ടോസുകോ ഹോൺജോയുടെ പേരിലുള്ള ഒരു വ്യാജ പ്രൊഫൈലാണ്.
2. അദ്ദേഹം അങ്ങനൊരു പ്രസ്താവന ഒരിടത്തും പറഞ്ഞിട്ടുമില്ല. ഏപ്രിൽ 10-ന് ജപ്പാനിലെ ഒരു ന്യൂസ് പോർട്ടലിന് നൽകിയ ഇൻറർവ്യൂവിലും കൊറോണയ്ക്ക് ശേഷം ലോകം മറ്റൊന്നായിരിക്കും എന്നേ പറയുന്നുള്ളു. വൈറസിനെ പറ്റി ഒന്നും പറഞ്ഞിട്ടില്ല.
3.അദ്ദേഹം വുഹാനിലെ ലാബിൽ ജോലി ചെയ്തിരുന്നു എന്നത് കള്ളമാണ്. അദ്ദേഹം ടോക്യോയിൽ കാൻസർ റിസർച്ച് ചെയ്യുന്ന ശാസ്ത്രജ്ഞനാണ്. വൈറോളജിസ്റ്റല്ലാ.
ഇതൊക്കെ അദ്ദേഹത്തിൻ്റെ തന്നെ വക്താക്കൾ അറിയിച്ചതാണ്. ഇത്രയും തന്നെ മതിയല്ലോ അതു വ്യാജസന്ദേശമാണെന്ന് മനസ്സിലാക്കാൻ..
അതേസമയം മറ്റൊരു നോബൽ സമ്മാന ജേതാവായ ഫ്രഞ്ച് വൈറോളജിസ്റ്റ് ലുക്ക് മൊണ്ടേനിയറും ഇതേ കാര്യം ഒരു ഇൻ്റർവ്യൂവിൽ പറഞ്ഞതായി വാർത്തകളുണ്ടായിരുന്നു. അദ്ദേഹത്തിൻ്റെ ആ വിവാദപ്രസ്താവന, ഫ്രാൻസിലെ മറ്റു വൈറോളജിസ്റ്റുകൾ തന്നെ തള്ളിക്കളഞ്ഞതാണ്. DNA യിൽ നിന്നും ഇലക്ട്രോമാഗ്നെറ്റിക് തരംഗങ്ങൾ ഉണ്ടാകുന്നുവെന്നും പപ്പായ എയ്ഡ്സിന് ചികിത്സയ്ക്ക് ഉപയോഗിക്കാം എന്നുമൊക്കെയുള്ള അശാസ്ത്രീയ പ്രസ്താവനകൾ നടത്തി നേരത്തേ വിവാദനായകനായ ആളാണ് ലുക് മൊണ്ടേനിയർ.
ഇനി ഇവരാരും പറഞ്ഞില്ലെങ്കിലും, അത് ഒരു മനുഷ്യനിർമ്മിത വൈറസ് ആയിക്കൂടെ എന്ന സംശയം പലർക്കുമുണ്ടാകാം. അതല്ലന്നെങ്ങനെ പറയും?
ഇതിനെപ്പറ്റി നിരവധി പരീക്ഷണങ്ങളും നിരീക്ഷണങ്ങളും നടന്നു കഴിഞ്ഞതാണ് ഇതിനകം. ഈ മാസം നേച്ചർ ജേണലിൽ പ്രസിദ്ധീകരിച്ച ലേഖനത്തിലും പറയുന്നത്, കൊവിഡിൻ്റെ ജനിതകപദാർത്ഥം ഒരു വൈറൽ ടെമ്പ്ലേറ്റ് വെച്ച് കൃത്രിമമായി നിർമ്മിച്ചതല്ല, അതിൻ്റേതായ തെളിവുകൾ ഒന്നും തന്നെ കണ്ടെത്താൻ കഴിഞ്ഞിട്ടില്ല എന്നാണ്. മുമ്പ് ലാൻസെറ്റിലും മറ്റു ചില ജേർണലുകളിലും ഇത് പ്രകൃതിപരമായ മ്യൂട്ടേഷൻ സംഭവിച്ച വൈറസാണെന്നും ലാബിൽ നിർമ്മിച്ചതല്ലെന്നും റിപ്പോർട്ടുകൾ വന്നതാണ്. ലോകാരോഗ്യ സംഘടനയും ഇതൊരു ജൈവായുധം ആയിരിക്കാനുള്ള സാധ്യതകൾ നേരത്തേ തള്ളിക്കളഞ്ഞതാണ്.
അതുകൊണ്ട് ഇപ്പോൾ നമ്മൾ ശ്രദ്ധിക്കേണ്ടത്, ഈ രോഗത്തെ പ്രതിരോധിക്കുന്ന നടപടികൾ ഊർജ്ജിതമാക്കുന്നതിനും അഥവാ രോഗവ്യാപനം ഇനിയും തുടർന്നാൽ സ്വീകരിക്കേണ്ട നടപടികളെപ്പറ്റിയും ഒക്കെയാണ്. വ്യാജ സന്ദേശങ്ങൾ നിർമിക്കുകയും പ്രചരിപ്പിക്കുകയും ചെയ്യുന്നതിന് പിന്നിൽ പല ഗൂഢലക്ഷ്യങ്ങളും ഉണ്ടാവാം. നമ്മൾ അതിന് കൂട്ടു പിടിക്കേണ്ട കാര്യമില്ല.
നമ്മുടെ പ്രാഥമികലക്ഷ്യം നമുക്കും നമ്മുടെ ചുറ്റുമുള്ളവർക്കും രോഗം വരാതെ നോക്കുന്നതിനാവണം. അതുകൊണ്ട് മനുഷ്യന് എന്തെങ്കിലും ഉപയോഗമുള്ള സന്ദേശങ്ങൾ മാത്രം ഷെയർ ചെയ്യാൻ ശ്രദ്ധിക്കുക..